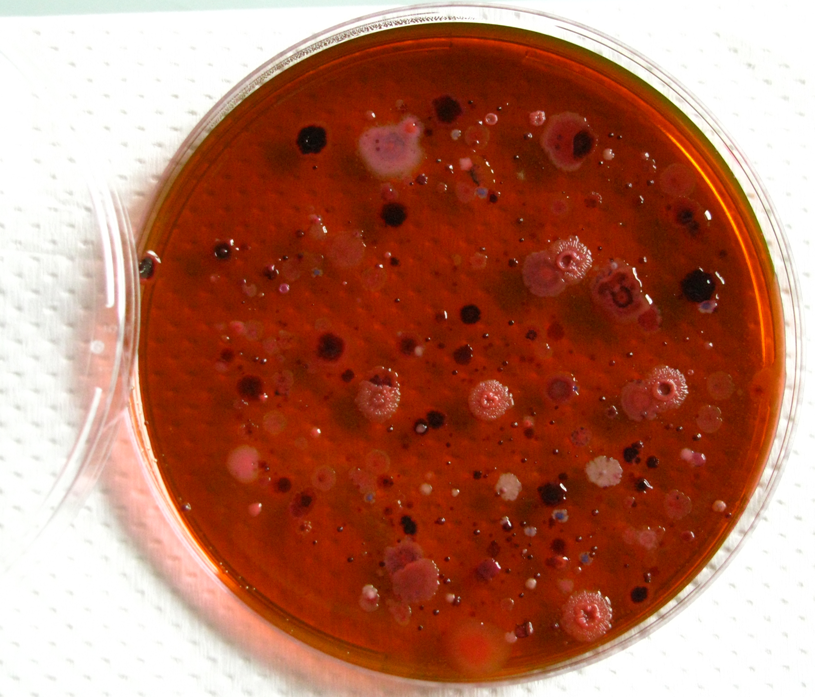

Fachtagung
Abwassermesstechnik im Zeitalter der Digitalisierung
Entscheide benötigen Informationen!
Die Erhebung von Daten, die zu Informationen führen, ist in der Abwasserreinigung eine Herausforderung ... mehr ....
09.11.2017